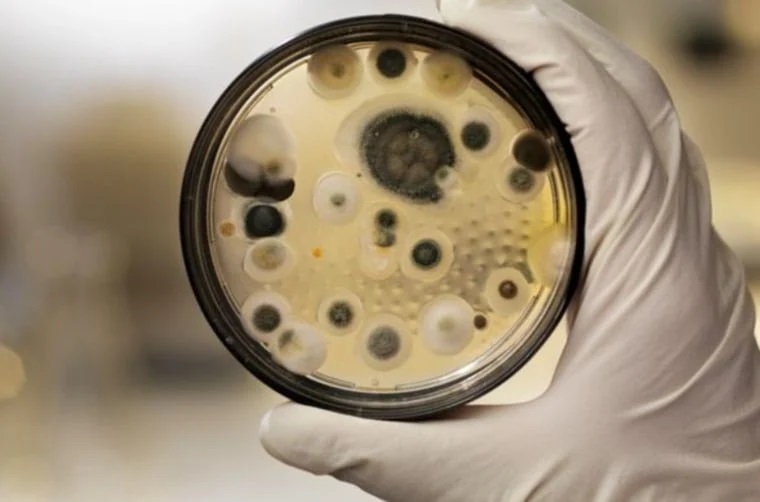

أخبارنا المغربية - وكالات
تمكّن باحثون من جامعة بنسلفانيا الأمريكية من تحويل فطر سام ارتبط تاريخياً بموت غامض إلى مصدر محتمل لعلاج فعال ضد سرطان الدم، في اكتشاف قد يغيّر مستقبل علاجات الأورام. الفطر المعروف باسم Aspergillus flavus أو "الرشاشيات الصفراء" عُرف بصلته بما يُعرف بـ"لعنة الفراعنة"، بعد أن اُتهم بالتسبب في حالات وفاة غامضة أعقبت فتح مقابر فرعونية قديمة.
الفريق البحثي، بقيادة البروفيسورة شيري غاو، نجح في عزل مركبات نشطة حيوياً من هذا الفطر أُطلق عليها اسم "أسبيريجيميسين"، تنتمي إلى فئة نادرة من الجزيئات المعروفة بـ RiPPs. هذه الجزيئات أظهرت فعالية واعدة في محاربة خلايا سرطان الدم، متفوقة في بعض حالاتها على أدوية تقليدية مستخدمة منذ عقود مثل السيتارابين.
الأبحاث أظهرت أن فعالية هذه الجزيئات تعتمد على جين محدد داخل الخلايا السرطانية يُدعى SLC46A3، الذي يعمل كمنفذ يسمح بدخول المركبات إلى داخل الخلايا، حيث تقوم بتعطيل عملية الانقسام الخلوي. وتم تعديل الجزيئات بإضافة سلسلة دهنية زادت من كفاءتها، دون أن تؤثر على خلايا الجسم السليمة أو أنسجة سرطانية أخرى.
ويتميّز الاكتشاف بدقّته العالية، إذ إن تأثير الجزيئات اقتصر على خلايا سرطان الدم دون التأثير على خلايا الثدي أو الكبد أو الرئة، وهو ما يفتح المجال لتطوير علاجات "موجّهة" بدقة، تقلل من الآثار الجانبية الشائعة للأدوية الكيميائية التقليدية.
يرى الفريق أن هذا الإنجاز قد يكون بداية فقط، مع ترجيحات بوجود مئات الأنواع من الفطريات التي لم تُكتشف بعد وتُخفي داخلها مركبات مشابهة. وعلّق الباحث تشيويو ني قائلاً: "لقد بدأنا لتوّنا باستكشاف صيدلية الطبيعة التي ظلت مخفية داخل الفطريات لآلاف السنين".
